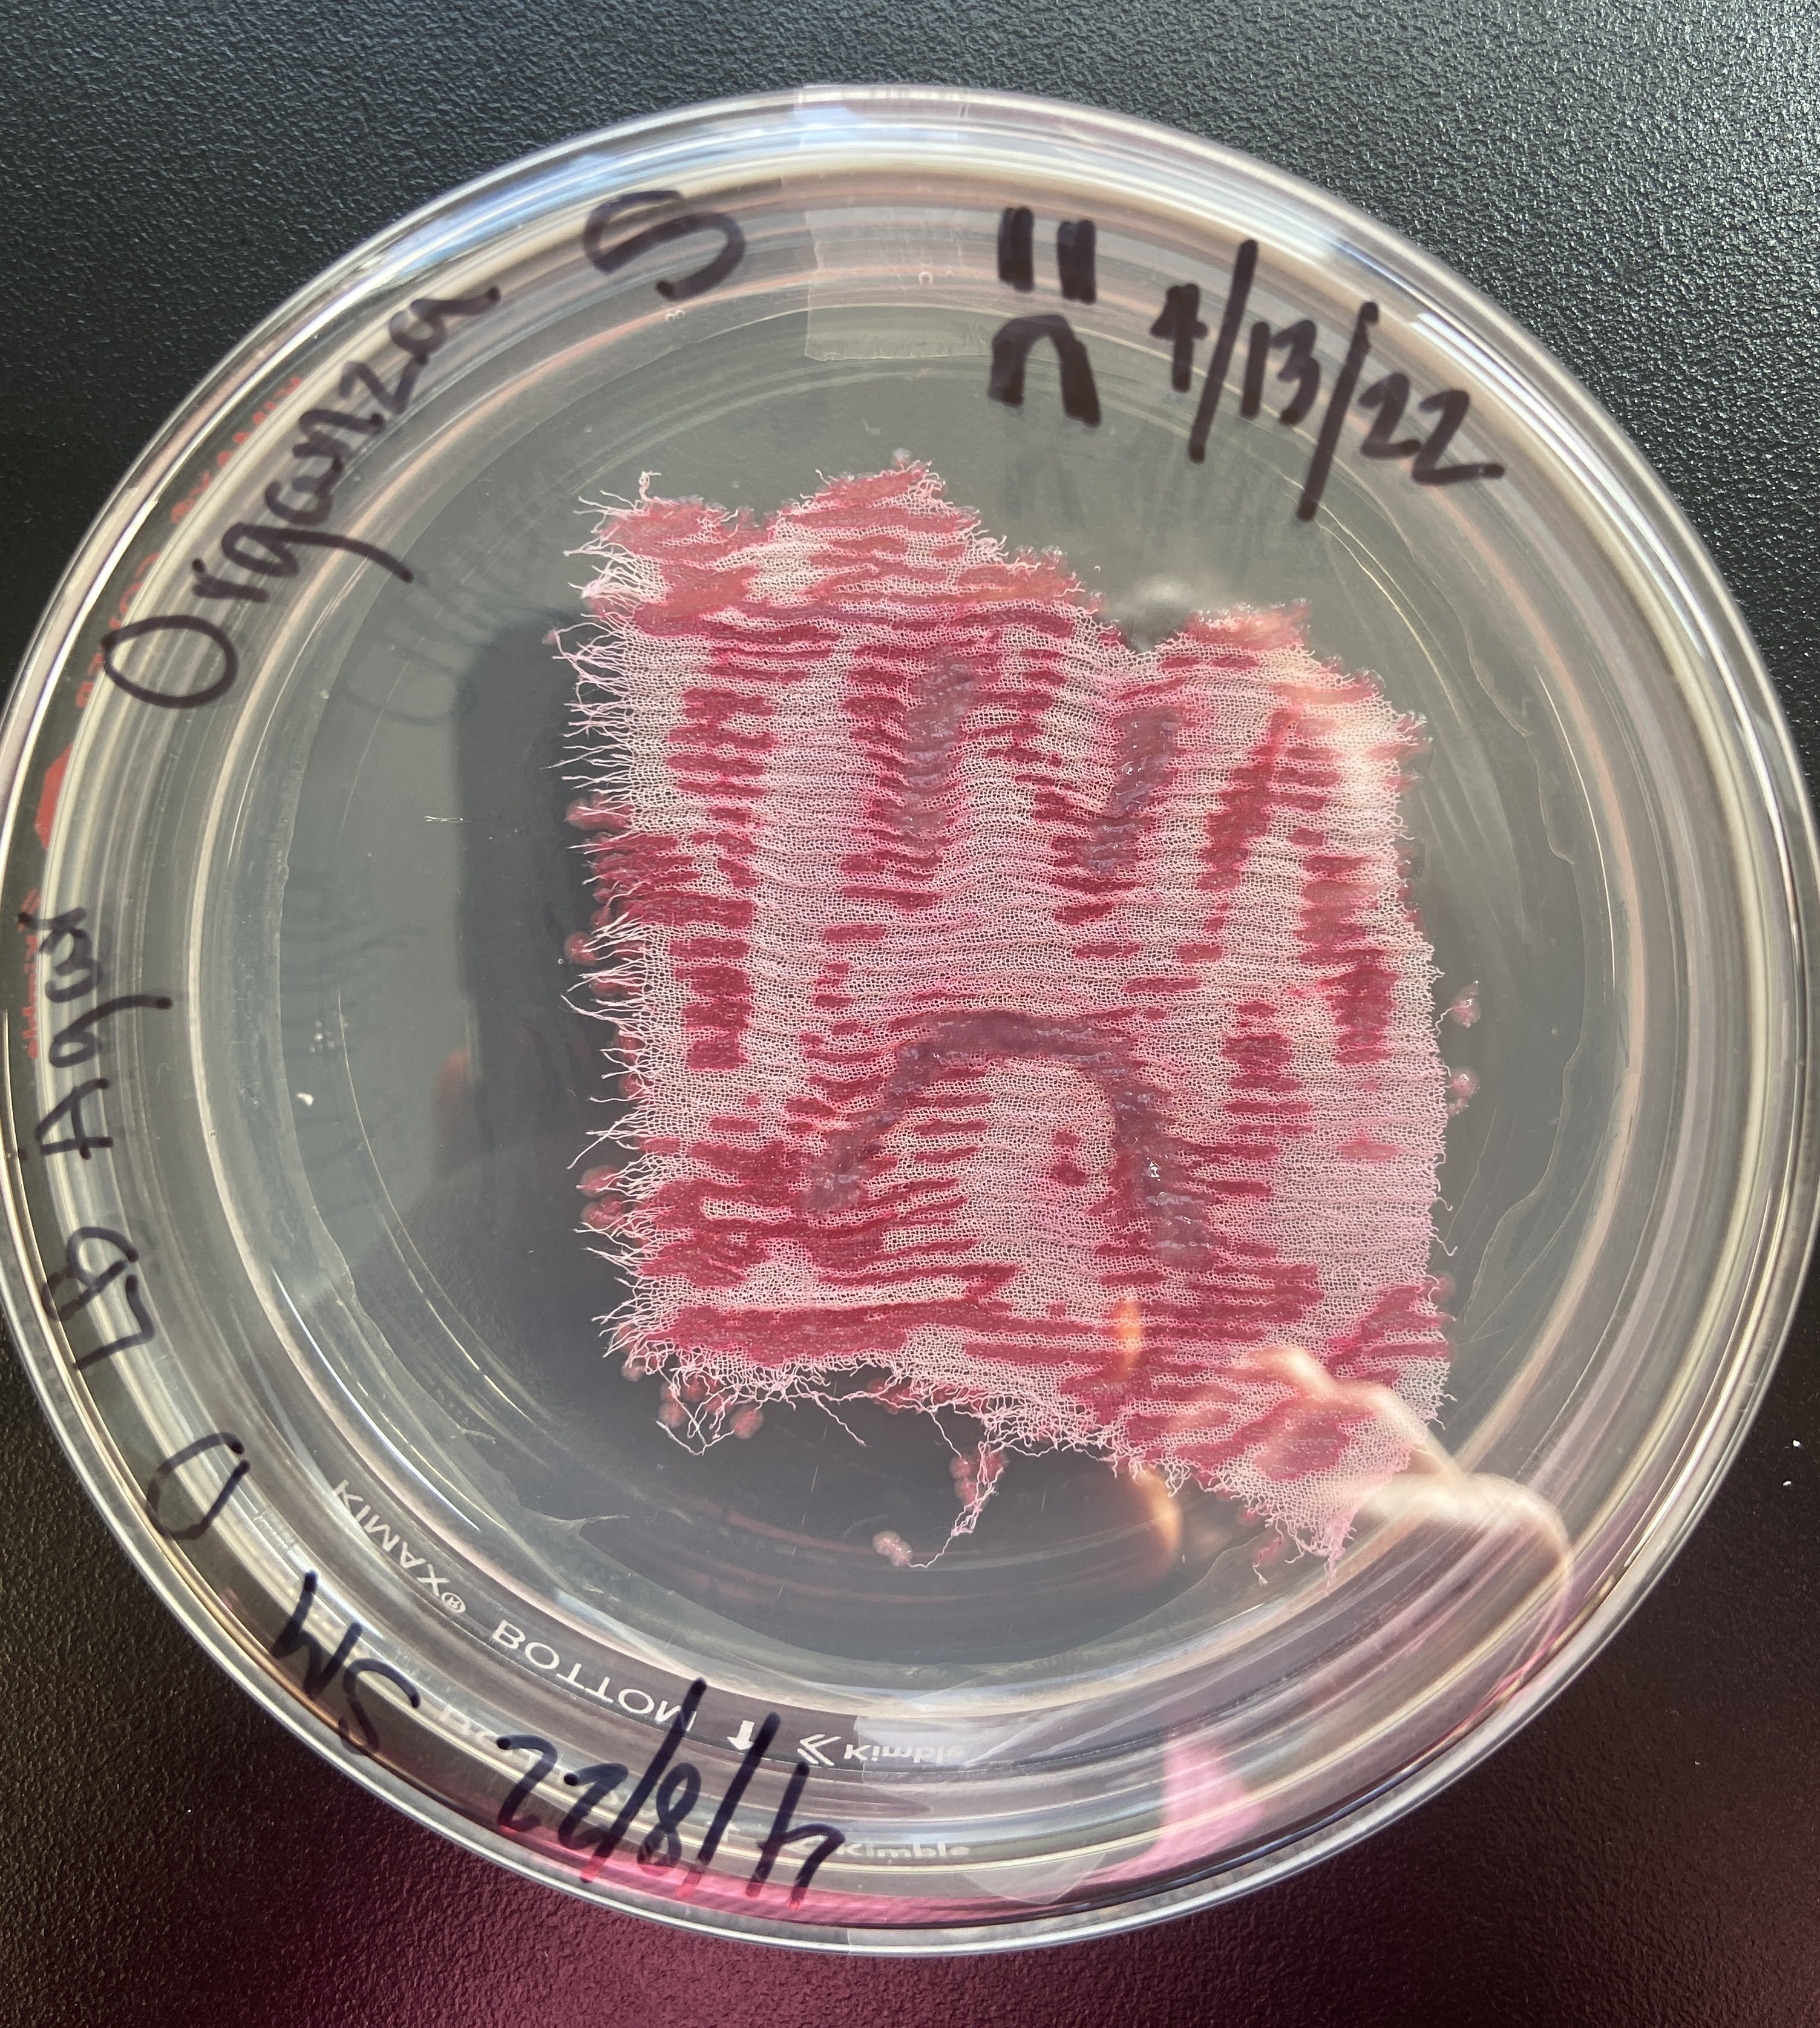
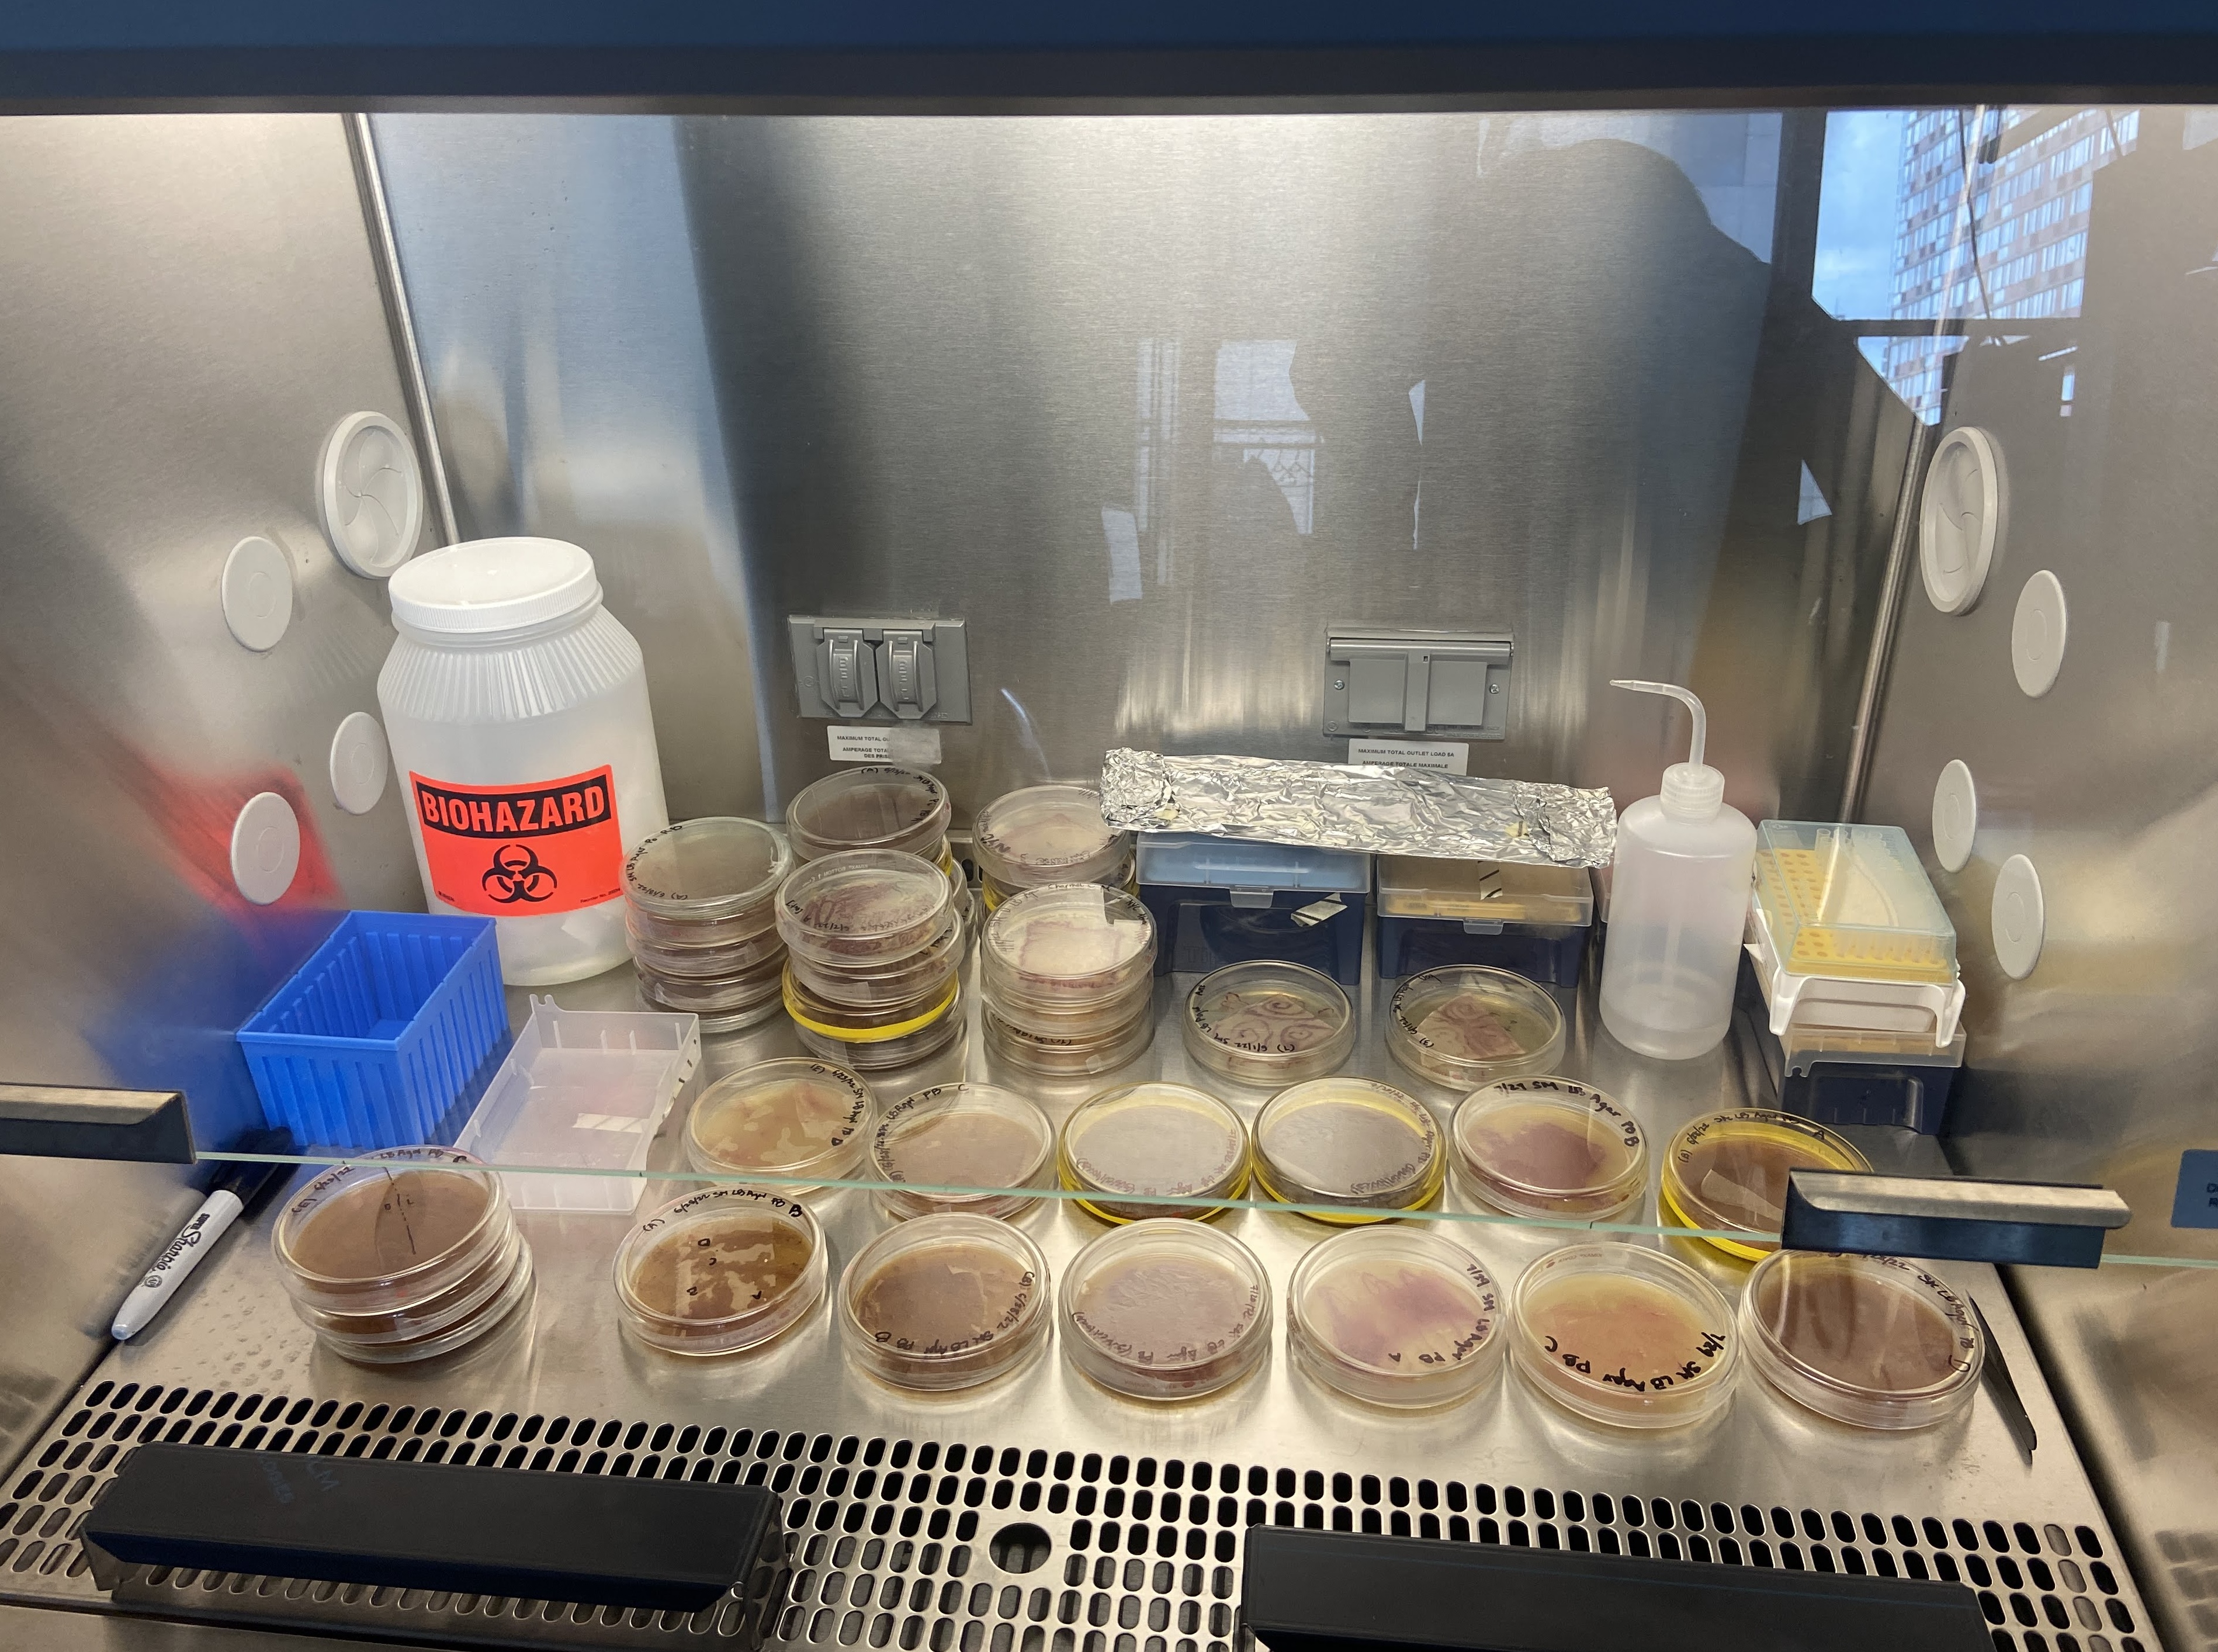

BIOMATERIALS
Co-collaborator – S. MarcescensProject advisor – Dr. Elizabeth Hénaff, NYU Tandon School of Engineering


If 20% of global clean water is polluted from textile dyeing and finishing (EU Parliament, 2024), could we reconcile fashion's pollution problem with biology?
I independently researched the intersection of biomaterials x sustainable fashion by experimenting with the inoculation of Serratia marcescens onto silk fabrics.
You know the smell of the earth after it rains? That’s S. Marcescens – a pigment-producing bacteria that’s found in soil and water. The more acidic environment, the brighter the pigment. Coincidentally, peanut butter’s acidity can potentially bump up the vibrancy of the pigments S. Marcescens produces.
Though materiality is important, systems are too. The future of sustainable fashion doesn't exist solely in choice of materials, but also the systems in how we produce, circulate, and move fashion.
Let’s just say, I left this project with more questions than I did answers.
I independently researched the intersection of biomaterials x sustainable fashion by experimenting with the inoculation of Serratia marcescens onto silk fabrics.
You know the smell of the earth after it rains? That’s S. Marcescens – a pigment-producing bacteria that’s found in soil and water. The more acidic environment, the brighter the pigment. Coincidentally, peanut butter’s acidity can potentially bump up the vibrancy of the pigments S. Marcescens produces.
Though materiality is important, systems are too. The future of sustainable fashion doesn't exist solely in choice of materials, but also the systems in how we produce, circulate, and move fashion.
Let’s just say, I left this project with more questions than I did answers.